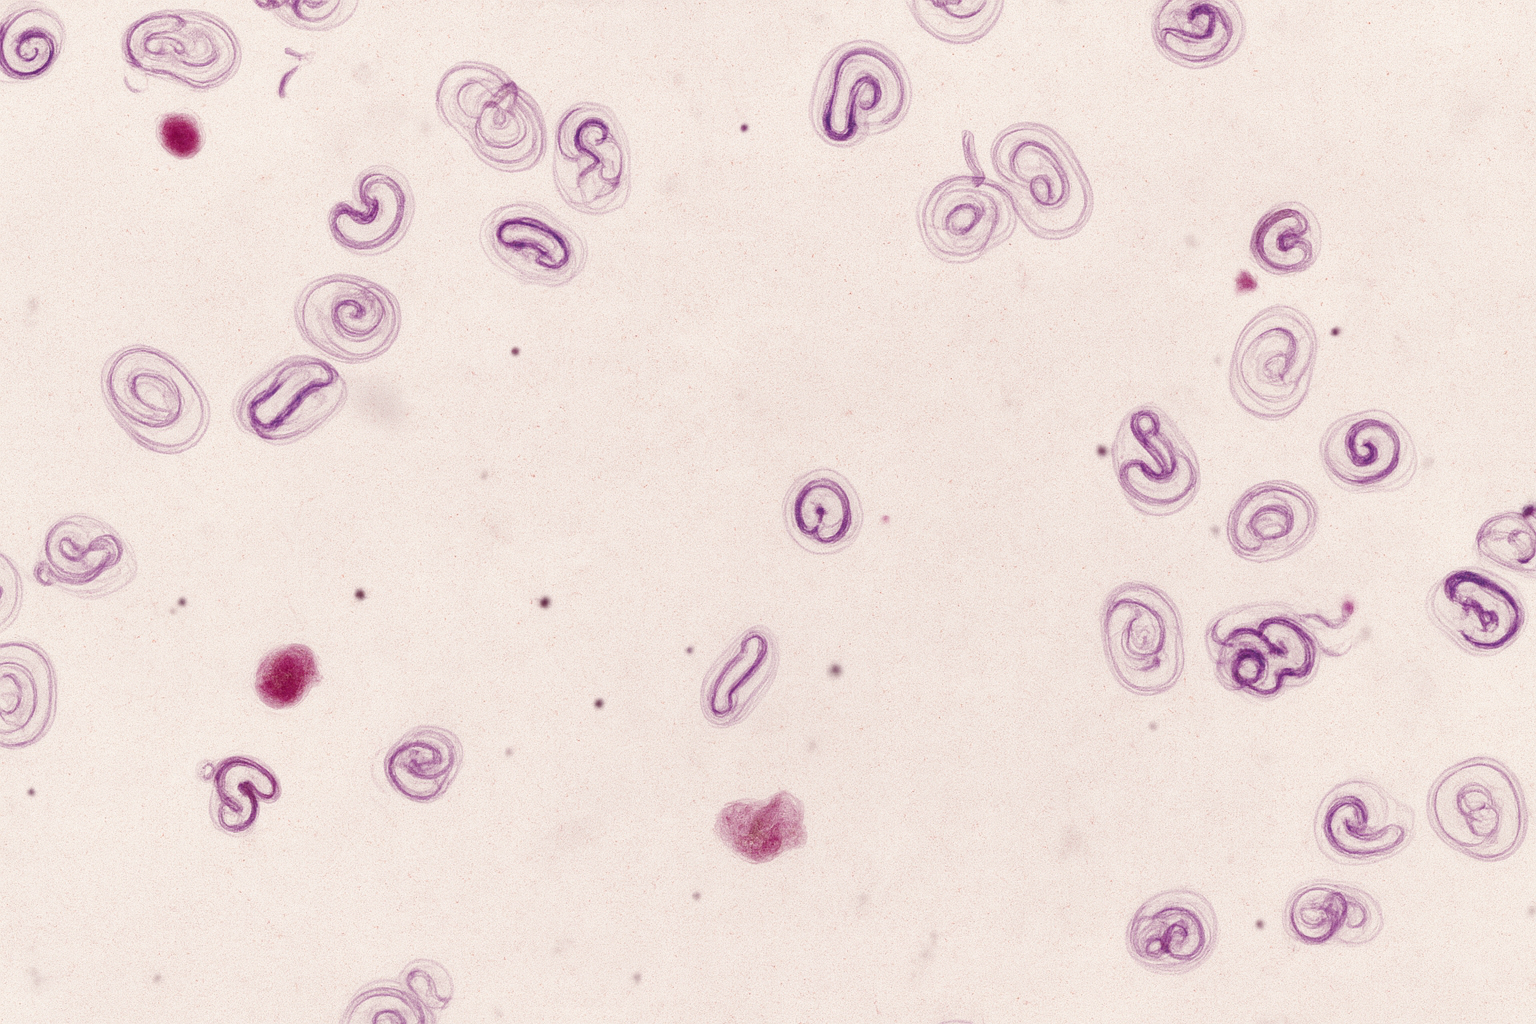

Threadworm infections (Strongyloides westeri) occur in young donkey foals. The source of infection for the foal is the mother. Shortly after birth, a dormant infection in the mother can become active, and larvae are transmitted to the foal through the mother’s milk. Within 10 days after ingestion, the larvae can already develop into adult worms in the foal, which then excrete eggs in the manure. The larvae that hatch from these eggs can penetrate the skin of the foal and reinfect the young animal.
Symptoms observed in young donkey foals up to about one month old include diarrhea, lethargy, weight loss, and refusal to drink milk. Fortunately, such infections are rare. The presence of the characteristic thin-walled eggs containing a larva confirms the infection. High egg counts can also be found in older donkey foals, but such infections rarely cause symptoms. If you suspect a severe threadworm infection, we recommend contacting your own veterinarian immediately so that treatment can be started as soon as possible. During manure testing, threadworm eggs are also counted, and advice for treatment can be given if necessary. If you want to know whether your donkey foal is infected with threadworms, we advise you to send in manure from your foal from 10 days of age. Good stable hygiene is essential to prevent serious infections. Therefore, remove (foal) manure daily, keep the stable dry, and replace bedding regularly.
If manure testing shows your donkey foal is infected with threadworm, we will provide you with a personalized treatment recommendation. This way, your foal’s health comes first and unnecessary deworming can be avoided. Please feel free to contact our team if you have any questions. Our enthusiastic team is happy to help!